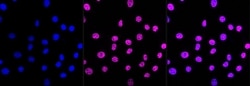
Invitrogen ARID1A Recombinant Rabbit Monoclonal Antibody (23GB3230), Invitrogen

missing translation for 'onlineSavingsMsg'
Learn More
Learn More
Invitrogen™ ARID1A Recombinant Rabbit Monoclonal Antibody (23GB3230), Invitrogen™


Rabbit Recombinant Monoclonal Antibody
Brand: Invitrogen™ MA553610
This item is not returnable.
View return policy
Description
This gene encodes a member of the SWI/SNF family, whose members have helicase and ATPase activities and are thought to regulate transcription of certain genes by altering the chromatin structure around those genes. The encoded protein is part of the large ATP-dependent chromatin remodeling complex SNF/SWI, which is required for transcriptional activation of genes normally repressed by chromatin. It possesses at least two conserved domains that could be important for its function. First, it has a DNA-binding domain that can specifically bind an AT-rich DNA sequence known to be recognized by a SNF/SWI complex at the beta-globin locus. Second, the C-terminus of the protein can stimulate glucocorticoid receptor-dependent transcriptional activation. It is thought that the protein encoded by this gene confers specificity to the SNF/SWI complex and may recruit the complex to its targets through either protein-DNA or protein-protein interactions. Two transcript variants encoding different isoforms have been found for this gene.
Specifications
| ARID1A | |
| Recombinant Monoclonal | |
| 0.8 mg/mL | |
| PBS with 50% glycerol and 0.02% sodium azide; pH 7.4 | |
| A2BH40, O14497 | |
| ARID1A | |
| A synthetic peptide of human ARID1A (1200-1400AA). | |
| 100 μL | |
| Primary | |
| Human, Mouse, Rat | |
| Antibody | |
| IgG |
| Flow Cytometry, Western Blot, Immunocytochemistry | |
| 23GB3230 | |
| Unconjugated | |
| ARID1A | |
| 1110030E03Rik; ARID domain-containing protein 1A; ARID1A; AT rich interactive domain 1A (Swi1 like); AT rich interactive domain 1A (SWI-like); AT-rich interaction domain 1A; AT-rich interactive domain-containing protein 1A; B120; BAF250; Baf250a; BM029; brain protein 120; BRG1-associated factor 250; BRG1-associated factor 250a; C1orf4; chromatin remodeling factor p250; CSS2; ELD; h BM029; hELD; hOSA1; MRD14; Osa homolog 1; Osa1; OSA1 nuclear protein; P270; Smarcf1; SWI/SNF complex protein p270; SWI/SNF related, matrix associated, actin dependent regulator of chromatin, subfamily f, member 1; SWI/SNF-related, matrix-associated, actin-dependent regulator of chromatin subfamily F member 1; Swi1 like; SWI-like protein; SWI-SNF complex protein p270 | |
| Rabbit | |
| Affinity Chromatography | |
| RUO | |
| 297867, 8289, 93760 | |
| -20°C | |
| Liquid |
Product Content Correction
Your input is important to us. Please complete this form to provide feedback related to the content on this product.
Product Title
Spot an opportunity for improvement?Share a Content Correction